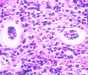
Angiostrongylus costaricensis eggs and larvae in tissue stained with hematoxylin and eosin (H&E).

DPDx is an education resource designed for health professionals and laboratory scientists. For an overview including prevention and control visit www.cdc.gov/parasites/angiostrongyliasis.
Angiostrongyliasis
[Angiostrongylus cantonensis] [Angiostrongylus costaricensis]
Click on a group of images to see larger images and more information.
Angiostrongylus costaricensis eggs and larvae in tissue stained with hematoxylin and eosin (H&E).
In humans, Angiostrongylus eggs and larvae are not normally excreted but remain sequestered in tissues. A. costaricensis infections are predominantly abdominal; both eggs and larvae (occasionally adult worms) can be identified in biopsy or surgical specimens of intestinal tissue where the eggs and larvae are engulfed in giant cells and/or granulomas. A. cantonensis infections are predominantly cerebral, being one of the most common causes of eosinophilic meningitis, although developing but immature adult worms can on occasion migrate to the lungs. No A. cantonensis eggs or larvae have been recognized in human tissues.
The larvae of A. costaricensis need to be distinguished from larvae of Strongyloides stercoralis. A. costaricensis first stage (L1) larvae tend to be slightly smaller in diameter than Strongyloides and have a single lateral ala, whereas Strongyloides third stage (L3) larvae have minute double lateral alae. The alae can be difficult to discern in most histologic sections. However, the presence of granulomas containing thin shelled eggs and/or larvae generally serve to distinguish A. costaricensis infections from Strongyloides infections.

Figure A: Angiostrongylus costaricensis eggs in intestinal tissue stained with hematoxylin and eosin (H&E).

Figure B: Thin-shelled A. costaricensis eggs in intestinal tissue stained with H&E, a feature consistent with the presence of mature female worms.

Figure C: A. costaricensisfirst stage (L1) larva in intestinal tissue stained with H&E
Angiostrongylus costaricensis adult female in tissue sections stained with H&E.

Figure A: Angiostrongylus costaricensis female worm in appendix tissue sections stained with hematoxylin and eosin (H&E). Image courtesy of Regions Hospital, St. Paul, MN.

Figure B: Higher magnification of the specimen in Figure A. Notice the thick, multinucleate intestine (IN) and eggs (EG) within the uterus (UT).

Figure C: Another image from the specimen seen in Figure A.

Figure D: Higher magnification of the specimen in Figure C. Shown here are the thick, multinucleate intestine (IN), reproductive tubes (RT), and lateral chords (LC).
Angiostrongylus sp. male worms.

Figure A: Angiostrongylus sp. male worm, approximately 4.25 mm in length, recovered from vitreous humor of a human patient. The worm is most likely A. cantonensis based on the patient's geographic location.

Figure B: Angiostrongylus worm. Note the very long spicules (black arrows), one of the indications that this is a male worm.

Figure C: Higher magnification of the worm in Figure B.

Figure D: Angiostrongylus adult worm recovered from vitreous humor of a human patient. The bursa is one indication that this is a male worm. The worm is most likely A. cantonensis based on the patient's geographic location.

Figure E: Same specimen as in Figure D but in a different focal plane.
A. cantonensis larvae recovered from slugs.
Third stage (L3), infective larvae would not be found in human tissue; the images below are not clinically diagnostic. L3 larvae are infective to humans, who serve as incidental hosts.

Figure A: Angiostrongylus cantonensis third stage (L3), infective larva recovered from a slug. Image captured under differential interference contrast (DIC) microscopy.

Figure B: A. cantonensis (L3), infective larvae recovered from a slug. Image captured under DIC microscopy.

Figure C: Higher magnification of Image B. Note the terminal projection on the tip of the tail which is characteristic of A. cantonensis.
A. cantonensis larvae recovered from slugs.

Figure A: Angiostrongylus cantonensis third stage (L3), infective larva, in a wet mount, recovered from a slug. Note the terminal projection on the tip of the tail which is characteristic of A. cantonensis.

Figure B: A. cantonensis L3, infective larvae, in wet mounts, recovered from slugs.

Figure C: A. cantonensis L3, infective larvae, in wet mounts, recovered from slugs.
 ShareCompartir
ShareCompartir